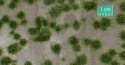
Dwukolorowe letnie tufty (15x8 cm)

-
Koszyk jest pusty
-
x

-
Koszyk jest pusty
-
x
-
Dwukolorowe letnie tufty (15x8 cm)




| Wysyłka w ciągu | 24 godziny |
| Cena przesyłki | 11.99 |
| Dostępność |
|
| Kod kreskowy | |
| EAN | 4048847637320 |
Dwukolorowe letnie tufty (15x8 cm)
-
Zestaw akcesoriów, które idealnie urozmaicą każdą scenerię. Te drobne detale sprawdzą się zarówno w dekoracji pojedynczych podstawek na figurki, jak i całych makiet, dioram i pól bitew.
Nadaj letniego klimatu swojej makiecie. Sięgnij po dwukolorowe kępki traw. Odnajdziesz je w zestawie MiniNatur.
Teraz możesz ozdobić nawet najdrobniejsze zakamarki swojego modelu. W zestawie znajdziesz gotowe kępki roślinne o wysokości 1 cm. Ich użycie jest niesamowicie proste - po prostu wyjmij kępki traw i przyklej do swojej makiety.
Dane producenta
Silhouette Modellbau GmbH
Buschingstrasse 5
82216 Maisach - Gernlinden
Germany
+49081426526611
info@mininatur.de
- Producenci